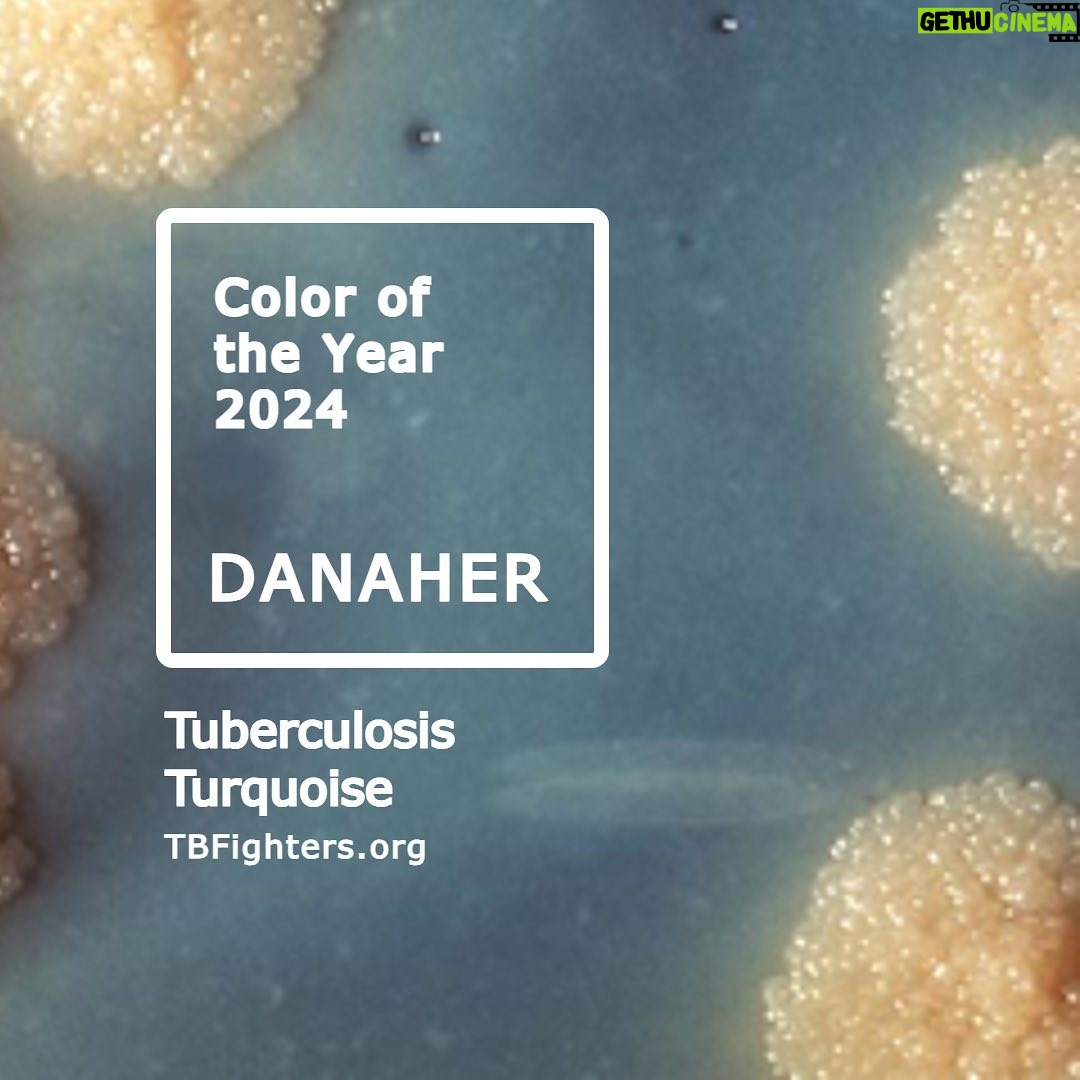

John Green Instagram – Football, even at its worst, can teach us about humanity. | Posted on 19/Jan/2023 08:36:58
Home Actor John Green HD Instagram Photos and Wallpapers January 2023 John Green Instagram - Football, even at its worst, can teach us about humanity.
Check out the latest gallery of John Green